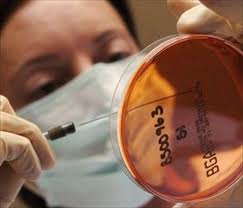
FibroStep:新型无创的肝纤维化分级工具.jpg

埃及开罗大学医院的研究者发现一种新型无创的肝纤维化分级工具可以代替肝活检或影像弹性成像技术评价不同的肝组织纤维化程度。具体内容:Liver Int. 2013 Aug;33(7):982-90.

研究目的
建立一种敏感、无创、免费的评价慢性HCV感染患者肝组织纤维化程度的方法。
研究方法
埃及开罗大学医院慢性丙型肝炎患者(n = 355)通过肝活进行肝纤维化分级(METAVIR),之后使用预选的肝纤维化无创标记进行检测。通过随机预测分析筛选出肝纤维化生物学标记,并建立了新型多级逐步肝纤维化的分析方法(FibroSteps),使用Logistic回归构建模型。FibroSteps预测肝纤维化分级需要4个步骤:第1步区分无(F0)/轻度(F1)肝纤维或中度(F2)/严重(F3)肝纤维化/肝硬化(F4);第2a步区分F0或F1;第2b步区别F2或F3/F4;第3步区分F3或F4。FibroSteps是通过随机筛选的训练组(n=234)患者建立起来,并且通过验证组(n=118)患者进行模型的最终优化及确定。
研究结果
透明质酸、肿瘤坏死因子β1,α2巨球蛋白,金属蛋白酶-2,载脂蛋白A1,尿素,金属蛋白酶-1,甲胎蛋白,结合珠蛋白,红细胞,血红蛋白以及基质金属蛋白酶组织抑制剂1被选入模型,其训练组和验证组患者受试者工作曲线下面积(AUROC)分别为0.973,0.923(第1步),0.943,0.872(第2a步);0.916,0.883(第2b步)以及0.944, 0.946(第3步)。两组患者最终分级准确度分别为94.9%(95% CI: 91.3–97.4%)和89.8% (95% CI: 82.9–94.6%)。
结论
FibroSteps是一种免费、无创的肝纤维化分级工具,可以准确的对肝组织纤维化分级进行判定,从而辅助临床医生制定预测性或治疗性措施。使用R软件进行FibroSteps分析的统计学代码在补充材料中予以提供。










